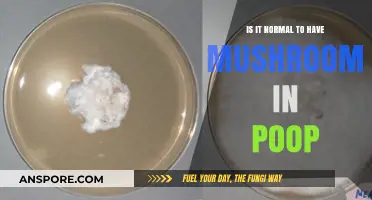
Mushrooms in Poop: Should You Be Concerned or Is It Normal?

In Florida, the legality of picking mushrooms largely depends on the location and the type of mushrooms being harvested. On private property, mushroom foraging is generally permitted with the landowner's consent, but it’s essential to ensure the mushrooms are not protected or endangered species. In state parks, wildlife management areas, and other public lands, picking mushrooms is often prohibited to preserve natural ecosystems and prevent habitat disruption. Additionally, some mushrooms, like the protected *Amanita muscaria* (fly agaric), may have specific legal restrictions. Foragers should also be cautious, as misidentifying mushrooms can lead to poisoning or legal consequences. Always check local regulations and obtain necessary permits before foraging in Florida.
| Characteristics | Values |
|---|---|
| Legality of Mushroom Foraging in Florida | Generally legal on public lands, but with restrictions and exceptions |
| State Laws | No specific state laws prohibiting mushroom picking for personal use |
| Federal Laws | No federal laws against mushroom foraging |
| Public Lands (e.g., State Parks, National Forests) | Allowed, but may require permits or have specific regulations (check with individual park/forest authorities) |
| Private Lands | Illegal without landowner permission |
| Protected Species | Picking endangered or threatened mushroom species is prohibited (e.g., certain Amanita species) |
| Commercial Harvesting | May require permits or licenses, depending on location and scale |
| Quantity Limits | Some public lands may impose limits on the amount of mushrooms that can be collected |
| Seasonal Restrictions | Certain areas may have seasonal closures to protect ecosystems |
| Identification Requirement | Collectors are responsible for correctly identifying mushrooms; misidentification can lead to legal consequences if protected species are harmed |
| Environmental Impact | Collectors must follow ethical foraging practices (e.g., no damaging mycelium, leaving some mushrooms for spore dispersal) |
| Local Ordinances | Some counties or municipalities may have additional regulations; check local laws |
| Penalties for Violations | Fines, confiscation of mushrooms, or other penalties for illegal harvesting or damaging protected species |
| Recommendation | Always verify rules with local authorities or land managers before foraging |
Explore related products
$10.07 $25.99
$13.99 $27.95
What You'll Learn

Florida mushroom foraging laws
In Florida, mushroom foraging laws are primarily governed by property rights and land management regulations, as there are no specific statewide laws that explicitly prohibit or permit the picking of mushrooms. However, this does not mean that foragers are free to collect mushrooms anywhere they please. The legality of mushroom foraging in Florida largely depends on the type of land you are on—public, private, or state-managed. Understanding these distinctions is crucial to avoid legal issues and to forage responsibly.
On private property, picking mushrooms without the landowner’s permission is considered trespassing and is illegal. Florida law protects private property rights, and unauthorized foraging can result in fines or other legal consequences. Always seek explicit permission from landowners before foraging on private land. This includes rural areas, farms, and even residential properties where mushrooms may appear to be "in the wild."
For public lands, such as local parks or city-managed green spaces, the rules vary by municipality. Some local governments may allow foraging for personal use, while others may prohibit it to protect natural resources. It is essential to check with local park authorities or review posted regulations before foraging. In many cases, public parks prioritize conservation and may restrict activities like mushroom picking to preserve ecosystems.
State parks and state-managed lands in Florida often have stricter regulations. The Florida Park Service generally prohibits the removal of any natural materials, including mushrooms, to protect biodiversity and maintain ecological balance. Foraging in state parks can result in fines or other penalties. Always consult the specific rules of the state park or wildlife management area you plan to visit, as regulations can differ between locations.
Additionally, federal lands, such as national forests or wildlife refuges, may have their own set of rules regarding mushroom foraging. For example, the Ocala National Forest allows personal-use mushroom collecting but requires adherence to specific guidelines, such as quantity limits and permitted species. Always verify the regulations with the managing federal agency before foraging on these lands.
In summary, while Florida does not have a blanket law against mushroom foraging, the activity is heavily influenced by property ownership and land management policies. To forage legally and responsibly, always identify the type of land you are on, obtain necessary permissions, and follow all posted regulations. Respecting these rules ensures the preservation of Florida’s natural habitats and avoids legal repercussions.
A Hearty Broccoli Rice Casserole: Cream of Mushroom?
You may want to see also

Protected mushroom species in Florida
In Florida, the legality of picking mushrooms is a nuanced topic, particularly when it comes to protected species. While there is no statewide law explicitly prohibiting the collection of all mushrooms, certain species are safeguarded due to their ecological importance, rarity, or endangered status. Understanding which mushrooms are protected is crucial for foragers to avoid legal consequences and contribute to conservation efforts. Florida’s diverse ecosystems, ranging from wetlands to forests, support a variety of fungi, some of which are under threat due to habitat loss, climate change, and overharvesting.
One of the most notable protected mushroom species in Florida is the *Amanita ponderosa*, commonly known as the Ponderosa mushroom. This species is not only ecologically significant but also plays a vital role in mycorrhizal relationships with native trees. Harvesting *Amanita ponderosa* is discouraged, especially in protected areas like state parks and wildlife reserves, where collecting any plant or fungal material is often prohibited. Additionally, the *Gomphidius roseus*, or the rosy gomphidius, is another species of concern due to its limited distribution in Florida’s pine forests. Foragers are advised to leave these mushrooms undisturbed to ensure their survival.
Florida’s rare and endangered fungi list also includes species like *Tricholoma floridanum*, a mushroom found exclusively in the state’s scrub habitats. These habitats are already under significant stress from development and invasive species, making the preservation of associated fungi critical. While not all rare mushrooms are officially listed as protected, ethical foraging practices dictate avoiding their collection. The Florida Fish and Wildlife Conservation Commission (FWC) and the Florida Department of Agriculture and Consumer Services (FDACS) provide guidelines and resources to help foragers identify species that should not be harvested.
It is important to note that protected areas, such as national parks, state parks, and wildlife management areas, have strict regulations against collecting any natural materials, including mushrooms. Even if a species is not explicitly protected, picking mushrooms in these areas is illegal. Foragers should always verify the rules of the specific location they are visiting and obtain any necessary permits. Ignorance of the law is not a defense, and violations can result in fines or other penalties.
To promote conservation, foragers in Florida are encouraged to practice sustainable harvesting methods, such as collecting only a small portion of mushrooms in an area and avoiding rare or endangered species altogether. Joining local mycological societies or attending workshops can provide valuable knowledge about protected species and ethical foraging. By respecting Florida’s fungal biodiversity, individuals can enjoy the hobby of mushroom hunting while contributing to the preservation of these vital organisms for future generations.
Mushroom Extract: A Natural Remedy for Bees
You may want to see also

Permits for mushroom picking in FL
In Florida, the legality of picking mushrooms depends largely on the location and the type of land you are foraging on. While there is no statewide law explicitly prohibiting mushroom picking, specific regulations and permits may apply, particularly on public lands such as state parks, national forests, and wildlife management areas. If you plan to forage for mushrooms in Florida, it is essential to understand the permitting requirements to avoid legal issues and protect natural resources.
For state parks and state-managed lands, the Florida Park Service generally allows mushroom picking for personal use but often requires a permit. The rules can vary by park, so it’s crucial to contact the specific park office or visit the Florida State Parks website for detailed information. Some parks may restrict foraging altogether to preserve ecosystems, while others may issue permits with strict guidelines on the quantity and species of mushrooms you can collect. Always inquire about permits and follow all posted regulations to ensure compliance.
On federal lands, such as those managed by the U.S. Forest Service (e.g., Ocala National Forest) or the U.S. Fish and Wildlife Service, mushroom picking may require a special use permit. For example, in national forests, personal-use mushroom foraging is often allowed without a permit, but commercial harvesting typically requires authorization. However, regulations can change, so it’s important to check with the local district office or visit the official website of the managing agency for the most up-to-date information. Failure to obtain the necessary permits can result in fines or other penalties.
Private lands in Florida are subject to the landowner’s rules. If you intend to pick mushrooms on private property, you must obtain explicit permission from the owner. Trespassing to forage mushrooms is illegal and can lead to legal consequences. Additionally, some landowners may require a written agreement or permit, especially if the foraging is for commercial purposes. Always respect private property rights and seek permission before collecting mushrooms.
For commercial mushroom harvesting in Florida, permits are almost always required, regardless of the land type. Commercial foragers must apply for the appropriate permits from the relevant state or federal agency. This process often involves fees, specific guidelines, and reporting requirements. Commercial harvesting without a permit is illegal and can result in significant fines or legal action. If you’re unsure about the permitting process, consult with the Florida Department of Agriculture and Consumer Services or the managing agency of the land in question.
In summary, while mushroom picking in Florida is not universally illegal, permits are often necessary, especially on public and federal lands. Always research the specific regulations for the area you plan to forage, obtain any required permits, and adhere to all guidelines. Responsible foraging ensures the preservation of Florida’s natural habitats and helps you avoid legal complications.
Mushrooms and Mental Clarity: Combating Brain Fog Naturally
You may want to see also
Explore related products

Penalties for illegal mushroom harvesting
In Florida, the legality of picking mushrooms depends on the location and the type of land. On private property, harvesting mushrooms without permission is considered trespassing and can lead to criminal charges. Penalties for trespassing in Florida include fines up to $500 and potential jail time of up to 60 days for a first offense. Repeat offenses can result in harsher penalties, including higher fines and longer jail sentences. It is crucial to obtain explicit permission from the landowner before foraging on private property to avoid these legal consequences.
On public lands, such as state parks or national forests, mushroom harvesting is generally regulated to protect natural resources. In Florida, many state parks prohibit the removal of any plant or fungal material, including mushrooms, without a permit. Violating these regulations can result in fines ranging from $50 to $500, depending on the severity of the offense. Additionally, individuals may face misdemeanor charges, which can include community service or probation. It is essential to check the specific rules of each public land area before foraging, as regulations can vary.
For federal lands, such as national forests in Florida, the penalties for illegal mushroom harvesting are governed by federal law. Under the Lacey Act, it is illegal to harvest plants or fungi in violation of state or federal regulations. Penalties can include fines of up to $10,000 and imprisonment for up to one year for individuals. Commercial violators may face even steeper fines, up to $20,000, and longer prison sentences. These federal penalties underscore the importance of adhering to all applicable laws when foraging on public lands.
In addition to criminal penalties, illegal mushroom harvesting can have ecological consequences, leading to further legal repercussions. Disturbing protected habitats or endangered species while foraging can result in additional fines and charges under environmental protection laws. For example, if harvesting mushrooms damages a protected ecosystem, individuals may face penalties under the Endangered Species Act or other conservation laws. These penalties can include substantial fines and restoration costs, emphasizing the need for responsible foraging practices.
To avoid penalties for illegal mushroom harvesting in Florida, individuals should familiarize themselves with local laws, obtain necessary permits, and respect private property rights. Joining local mycological societies or foraging groups can provide guidance on legal and sustainable practices. By adhering to regulations, foragers can enjoy the hobby while protecting natural resources and avoiding costly legal consequences. Always remember that ignorance of the law is not a valid defense, so proactive research is essential.
Do Road Trip Mushroom Gummies Work? A Comprehensive Review
You may want to see also

Public vs. private land regulations
In Florida, the legality of picking mushrooms hinges significantly on whether you are on public or private land, as regulations differ sharply between the two. On public land, such as state parks, national forests, or wildlife management areas, mushroom foraging is generally permitted for personal use, but with strict limitations. For instance, the Florida Fish and Wildlife Conservation Commission (FWC) and the Florida State Parks system allow the collection of small quantities of mushrooms for non-commercial purposes, typically limited to a few pounds per person per day. However, certain protected or endangered species, like the Florida Bonneted Bat Guano Fungus, may be off-limits entirely. Additionally, some public lands may require permits or have specific rules, so it’s essential to check with the managing agency beforehand.
In contrast, private land regulations are governed by property rights, meaning mushroom foraging is illegal without explicit permission from the landowner. Trespassing to pick mushrooms on private property can result in legal consequences, including fines or criminal charges. Even if mushrooms are visible from a public area, such as along a roadside or adjacent to private land, collecting them without permission is a violation of the law. Landowners in Florida have strong protections under state law, and unauthorized foraging can be treated as theft or trespassing. Always seek written consent from the landowner before foraging on private property.
Another key difference between public and private land is the enforcement of regulations. On public land, park rangers, forest service personnel, or FWC officers actively monitor and enforce rules, especially in protected or ecologically sensitive areas. Violations can result in citations, fines, or even bans from the area. On private land, enforcement is typically the responsibility of the landowner or local law enforcement, and penalties can be more severe, particularly if trespassing is involved. It’s crucial to respect boundaries and signage, as ignorance of the law is not a valid defense.
Foraging on public land also comes with ethical considerations, such as the impact on ecosystems. Overharvesting or damaging habitats can disrupt local flora and fauna, so foragers are encouraged to follow sustainable practices, like using knives to cut mushrooms rather than uprooting them. On private land, ethical considerations extend to respecting the landowner’s property and any specific requests they may have, such as avoiding certain areas or leaving no trace.
In summary, while picking mushrooms in Florida is not inherently illegal, the public vs. private land distinction is critical. On public land, foraging is generally allowed with restrictions, but always verify specific rules for the area. On private land, it is strictly prohibited without permission. Understanding and adhering to these regulations ensures compliance with the law and promotes responsible foraging practices.
The Ultimate Guide to Cleaning Chanterelles
You may want to see also
Frequently asked questions
It depends on the location. Picking mushrooms on private property without permission is illegal, while rules vary in public lands like state parks or forests. Always check local regulations.
Generally, no. Most Florida state parks prohibit the collection of plants, fungi, or wildlife to protect natural resources. Check specific park rules before foraging.
Some public lands may require permits for mushroom foraging, especially in protected areas. Contact the land management agency for details.
Penalties vary but can include fines or citations, especially in protected areas or if endangered species are involved.
Yes, but only with the landowner’s explicit permission. Trespassing to pick mushrooms is illegal and can result in legal consequences.